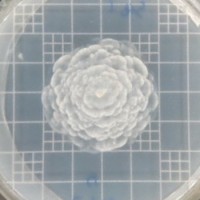
Luis Parra

Luis Parra work email
- Valid
Luis Parra personal email
As a sales and marketing professional, I specialize in helping individuals and companies with their sales strategy, email marketing, persuasive writing, negotiations, and B2B marketing. On the other hand, I have been playing the piano since the age of 8, and in addition to my own musical pursuits, I also assist other musicians by providing music practice solutions such as Muse Scene Lab.Additionally, I have a passion for finance and am able to assist with understanding money regulations, corporate and personal finance and crypto solutions in almost every area related to business or individuals.When I am not working, I love to travel and have developed a strategy for finding travel opportunities. In my free time, I enjoy helping others plan their business and holiday trips by finding the best deals on airline tickets and hotels. With my skills and experience, I am able to offer a unique and comprehensive approach to achieving success in various areas of business.Please, feel free to contact me if you need some of my help, I am more than open to have a talk on anything related to sales, marketing, finance, travels and sports as well!

-
 Co-Founder And CeoMuse Scene LabBarcelona, Ct, Es
Co-Founder And CeoMuse Scene LabBarcelona, Ct, Es -
 Co-Founder & CeoMuse Scene Lab Jul 2023 - PresentBarcelona, Cataluña, España
Co-Founder & CeoMuse Scene Lab Jul 2023 - PresentBarcelona, Cataluña, España -
 Co-Founder & CooMuse Scene Lab Apr 2022 - Jul 2023Madrid, Comunidad De Madrid, España
Co-Founder & CooMuse Scene Lab Apr 2022 - Jul 2023Madrid, Comunidad De Madrid, España -
 Co-Founder & CooThe Outsources Nov 2019 - Oct 2022Oklahoma, Estados UnidosThe Outsources is a company focus on lead generation for the B2B sector. We typically work with companies to increase their outbound sales strategy or engagement with high-quality leads. Generally, the businesses we work with are frustrated with misinformation given to them, with how much time their salespeople now spend not making sales, and have perhaps lost trust in the market place because of the misinformation.
Co-Founder & CooThe Outsources Nov 2019 - Oct 2022Oklahoma, Estados UnidosThe Outsources is a company focus on lead generation for the B2B sector. We typically work with companies to increase their outbound sales strategy or engagement with high-quality leads. Generally, the businesses we work with are frustrated with misinformation given to them, with how much time their salespeople now spend not making sales, and have perhaps lost trust in the market place because of the misinformation. -
 Entrepreneur In Residence - Incubation ProgramDemium Apr 2022 - Sep 2022Madrid, Comunidad De Madrid, España
Entrepreneur In Residence - Incubation ProgramDemium Apr 2022 - Sep 2022Madrid, Comunidad De Madrid, España -
 Account ExecutiveNovicap Jun 2017 - Sep 2019Barcelona Y Alrededores, España
Account ExecutiveNovicap Jun 2017 - Sep 2019Barcelona Y Alrededores, España -
 Business Development SpecialistNovicap Mar 2015 - Jun 2017Barcelona Y Alrededores, EspañaNovicap es una plataforma 'on line' de descuento de facturas y pagarés para pequeñas y medianas empresas.NoviCap ha desarrollado el primer algoritmo de análisis de riesgo automático, tan solo tienes que introducir el CIF de una empresa y la plataforma calcula el riesgo en menos de 30 segundos. Dando el volumen de línea disponible y el interés para cada uno de tus clientes. NoviCap se diferencia de los bancos tradicionales con las siguientes ventajas: - Flexible y ágil, todo de forma "online". Sin ir al notario - No afectamos a la CIRBE - Capacidad de gestionar el riesgo financiero. - Especializados en la Administración Pública - No hay venta cruzada ni costes por estudio o no disposición.
Business Development SpecialistNovicap Mar 2015 - Jun 2017Barcelona Y Alrededores, EspañaNovicap es una plataforma 'on line' de descuento de facturas y pagarés para pequeñas y medianas empresas.NoviCap ha desarrollado el primer algoritmo de análisis de riesgo automático, tan solo tienes que introducir el CIF de una empresa y la plataforma calcula el riesgo en menos de 30 segundos. Dando el volumen de línea disponible y el interés para cada uno de tus clientes. NoviCap se diferencia de los bancos tradicionales con las siguientes ventajas: - Flexible y ágil, todo de forma "online". Sin ir al notario - No afectamos a la CIRBE - Capacidad de gestionar el riesgo financiero. - Especializados en la Administración Pública - No hay venta cruzada ni costes por estudio o no disposición. -
Analista FinancieroBolsa De Valores De Barcelona Mar 2014 - Oct 2014Passeig De Gracia, 19Durante mi estadía con la Bolsa, desarrolle labores de análisis diario, semanal y mensual de las principales bolsas del mundo, en especial las Europeas. Utilicé herramientas como Bloomberg, Reuters y otras para desarrollar los informes a publicar en el portal web de la institución.
-
 SocioVision Travel Group Jun 2013 - Mar 2014Todo El MundoViaja por el mundo y conoce las nuevas oportunidades de negocio que tenemos para ti:www.agenciadeviajesvirtual.com/24601
SocioVision Travel Group Jun 2013 - Mar 2014Todo El MundoViaja por el mundo y conoce las nuevas oportunidades de negocio que tenemos para ti:www.agenciadeviajesvirtual.com/24601 -
AministradorLook Factory C.A. Aug 2009 - Sep 2013Comencé como asistente administrativo en Agosto del año 2009 en la empresa de la familia. Implementamos estrategias de ventas para aumentar los ingresos lo cual produjo la apertura de la segunda sucursal en la ciudad. En épocas de crisis se realizó un trabajo enfocado en el aspecto financiero-administrativo del negocio, en donde se demostró el problema de momento.
-
Profesor De PianoCcmtc Feb 2011 - Aug 2013Di clases a niños, adolescentes y adultos de todas las edades y en categorías desde principiante a nivel intermedio. Enseñé a tener un mejor control mental y automotor al tocar un instrumento musical.Motivé a los estudiantes a tener compromiso consigo mismos para mantener una disciplina al estudiar.
Luis Parra Skills
Luis Parra Education Details
-
 Entrepreneurship/Entrepreneurial Studies
Entrepreneurship/Entrepreneurial Studies -
 Financial Markets
Financial Markets -
 CeateFinanzas, General
CeateFinanzas, General -
 Finanzas, General
Finanzas, General -
 Escuela De Música Sebastián Echeverría LozanoMusic Performance, General
Escuela De Música Sebastián Echeverría LozanoMusic Performance, General -
 Centro De Capacitación Musical Teresa CarreñoMusic Performance, General
Centro De Capacitación Musical Teresa CarreñoMusic Performance, General
Frequently Asked Questions about Luis Parra
What company does Luis Parra work for?
Luis Parra works for Muse Scene Lab
What is Luis Parra's role at the current company?
Luis Parra's current role is Co-Founder and CEO.
What is Luis Parra's email address?
Luis Parra's email address is lu****@****cap.com
What schools did Luis Parra attend?
Luis Parra attended Escola Universitaria Politecnica De Mataro (Tecnocampus), Universitat Pompeu Fabra, Ceate, Universidad De Carabobo, Escuela De Música Sebastián Echeverría Lozano, Centro De Capacitación Musical Teresa Carreño.
What are some of Luis Parra's interests?
Luis Parra has interest in Social Services, Economic Empowerment, Education, Science And Technology, Arts And Culture.
What skills is Luis Parra known for?
Luis Parra has skills like Microsoft Office, Estrategia Empresarial, Microsoft Excel, Trabajo En Equipo, English, Liderazgo De Equipos, Financial Analysis, Economics, Teamwork, Microsoft Word, Team Leadership, Ventas.
Not the Luis Parra you were looking for?
-
Luis Parra
Madrid -
-
-
Free Chrome Extension
Find emails, phones & company data instantly
Aero Online
Your AI prospecting assistant
Select data to include:
0 records × $0.02 per record
Download 750 million emails and 100 million phone numbers
Access emails and phone numbers of over 750 million business users. Instantly download verified profiles using 20+ filters, including location, job title, company, function, and industry.
Start your free trial